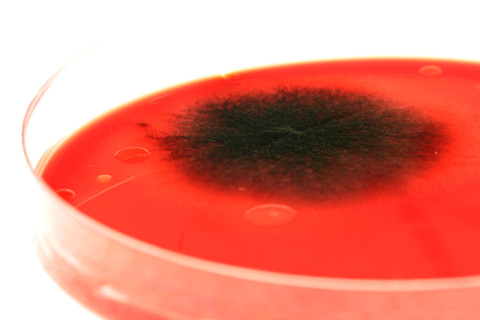
antibiotic-resistant-bacteria.jpg
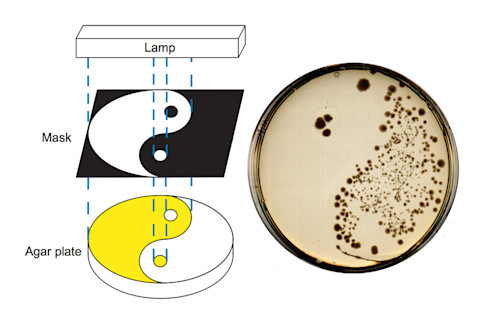
agar-plate.jpg

抗生素是救命的药物,但它们会在体内造成很多附带损害——副作用包括恶心到阴道酵母菌感染。 此外,一旦它们从体内排出,它们会通过在环境中积累并产生抗生素耐药性而造成各种破坏。 然而,一种新型抗生素可能会避免这种副作用,通过拨动灯的开关,仅在需要的时间和地点打开。正如 BBC描述的那样,
基本概念是为药物分子配备化学成分,这些成分会根据热或光改变形状......药物与其靶标结合的方式通常取决于它是否具有与靶酶上的“槽”精确匹配的形状。 因此,如果药物改变形状,它可能不再起作用。
这个想法是服用药物,但仅在身体的相关部位打开它们——并且仅在完成工作所需的时间内打开。 然后,这些智能抗生素被编程为在数小时内关闭,然后再释放到环境中。 根据 BBC 的说法,
吞服时,[抗生素] 往往会攻击肠道中的“友好”细菌以及病原体。 配备激活开关的药物可以口服,然后在到达身体(例如喉咙或肺部)中潜伏着有害细菌的部位后,用光打开。
该研究中的原型发表在最近的自然化学中,依靠紫外线来翻转抗生素的“开启”开关。 但是紫外线对患者来说不是很好,因此研究人员现在正在研究一种可以使用可见光或红外光的抗生素版本。
在该研究中,研究人员使用紫外线开启抗生素。 仅在遮罩阻止光线到达培养皿并开启抗生素的地方才会发生这种琼脂培养皿上的细菌生长。 图片来源:Willem A. Velema 等人/自然化学 鉴于 CDC 在 9 月份发布的 超级细菌状况报告,这些“智能”药物可以通过防止抗生素在环境中积累来提供一线希望。 尽管这项研究只是一个概念验证,但它在隧道尽头提供了一种抗生素激活光。 顶部图片来源:Dlumen/Shutterstock













